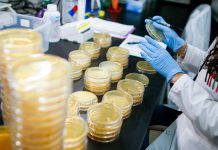
Coronavirus en IL: confirman 4 casos y 286 personas bajo revisión – Telemundo Chicago

Los expertos de la agencia ofrecieron los primeros cálculos para la caída que va a experimentar la economía este año.
El parón económico causado por las medidas tomadas por los gobiernos para luchar contra la propagación del coronavirus causará una recesión global este año, pronostica la agencia de calificación de riesgos S&P Global, que prevé asimismo un aumento superior al 10 % en las tasas de morosidad corporativa en EE.UU.
«La repentina parada económica causada por las medidas de contención de covid-19 llevará a una recesión global este año», dicen los expertos en un nuevo informe que Reuters recoge este martes. Asimismo, señalan que una caída en el flujo monetario y unas condiciones financieras mucho más estrictas, en paralelo a la sacudida provocada por el desplome de los precios del petróleo, afectarán a la solvencia crediticia.
![]()
A su juicio, es probable que «estos factores provoquen un aumento de los impagos, con una tasa de incumplimiento en las empresas no financieras de Estados Unidos que puede subir por encima del 10 % y alcanzar dígitos altos en Europa en los próximos 12 meses».
Por su parte, el ministro de Finanzas de Francia, Bruno Le Maire, pronosticó este martes una reducción del 1 % del PIB de su país en el 2020 y prometió ayudas del Estado directas e indirectas para hacer frente a la situación.
Si te ha gustado, ¡compártelo con tus amigos!


![WhatsApp sería destronado ante clásico rival que añadió increíbles funciones [FOTOS] – LaRepública.pe](https://www.condesi.pe/blog/wp-content/uploads/2019/10/nmprofetimg-28-218x150.png)